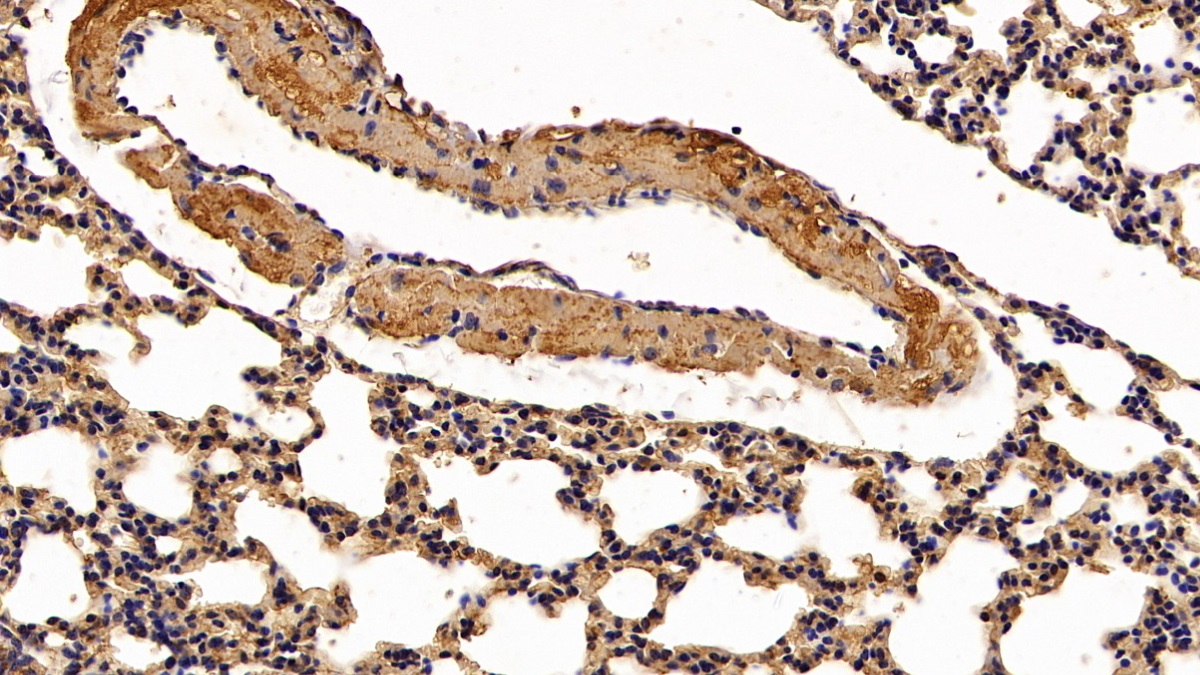
夏科雷登氏结晶蛋白(clc)多克隆抗体

夏克雷登结晶

隐形的宝剑夏科雷登结晶
图片尺寸800x659
大便常规镜检夏科雷登结晶
图片尺寸4032x3024
隐形的"宝剑"——夏科-雷登结晶
图片尺寸640x488
夏科莱登结晶
图片尺寸599x449
真菌胆固醇结晶夏科雷登结晶淀粉颗粒花粉植物细胞灵芝孢子肝吸虫卵
图片尺寸578x433
隐形的宝剑夏科雷登结晶
图片尺寸781x737
隐形的宝剑夏科雷登结晶
图片尺寸800x753
镜下多见下图所示两端细长针状结晶,请教各位同僚,这属于夏科雷登结晶
图片尺寸640x853
将大便标本混悬液混匀,生理盐水涂片镜检,发现竟然有夏科-雷登结晶!
图片尺寸468x351
▼「夏科-雷登结晶」83来源:粪便-未染色
图片尺寸660x371
上班以来最好看的结晶:夏科雷登结晶
图片尺寸576x432
science重磅夏科雷登结晶百年之谜被解开或将开启治疗哮喘新时代
图片尺寸799x480
粪便常规检查中检出夏科-雷登结晶一例
图片尺寸600x607
红细胞真菌胆固醇结晶夏科雷登结晶淀粉颗粒花粉植物细胞灵芝孢子肝
图片尺寸578x433
夏科雷登氏结晶蛋白(clc)多克隆抗体
图片尺寸1200x675
夏科雷登氏结晶蛋白(clc)多克隆抗体
图片尺寸1200x675
2018年细胞形态学培训考试 a:尿酸钠结晶 b: 尿酸结晶 c:夏科雷登结晶
图片尺寸2441x1728
▼「夏科雷登结晶」形态特征:为菱形无色透明指南针样,其两端尖长
图片尺寸750x575
图1 紫色标记的为夏科--雷登结晶,绿色标记的为霉菌.
图片尺寸543x254
上班以来最好看的结晶:夏科雷登结晶
图片尺寸576x432